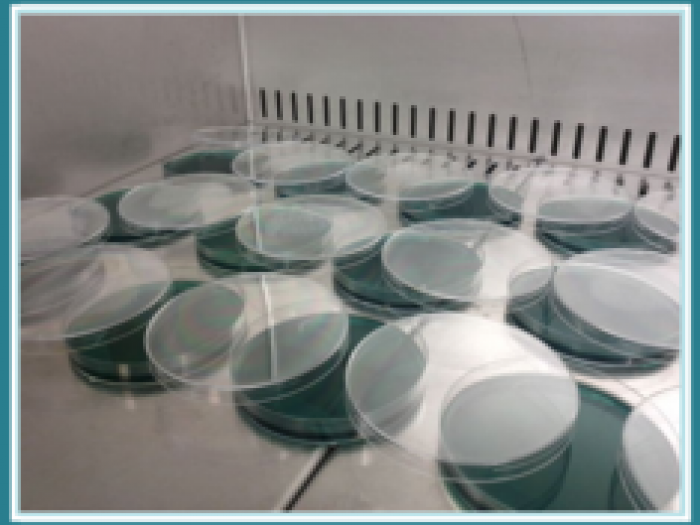
Archisio - Hydronatural - Progetto Analisi chimiche

Hydronatural
Analisi chimiche - Asti (AT)
Analisi chimiche
Vedi gli altri progetti
ARCHISIO
Invia una richiesta di lavoro a Hydronatural
Trova i migliori Manutenzione Verde a
Roma| Milano| Napoli| Torino| Palermo| Genova| Bologna| Firenze| Bari| Catania| Venezia| Verona| Messina| Padova| Trieste| Taranto| Brescia| Parma| Prato| Modena| Perugia| Ravenna| Livorno| Cagliari
Vedi tutti
Trova altri professionisti a Asti
Architetti| Imprese Edili| Imprese di Impianti Elettrici ed Elettricisti| Imprese di Traslochi| Imprese di Ponteggi| Imprese di Costruzioni Ecologiche| Ingegneri Edili| Imprese di Tende da Interni| Imprese di Bonifica Eternit| Rivenditori di Arredo Giardino ed Esterni| Rivenditori di Camini e Stufe| Rivenditori di Cucine| Geometri| Rivenditori di Illuminazione| Rivenditori di Arredamento| Rivenditori di Pavimenti e Rivestimenti| Fotografi di Interni| Rivenditori di Piscine| Designer di Interni| Artisti| Imprese di Tinteggiature| Parquettisti| Marmisti| Imprese di Impianti di Climatizzazione
Vedi tutti
Manutenzione Verde vicino a te